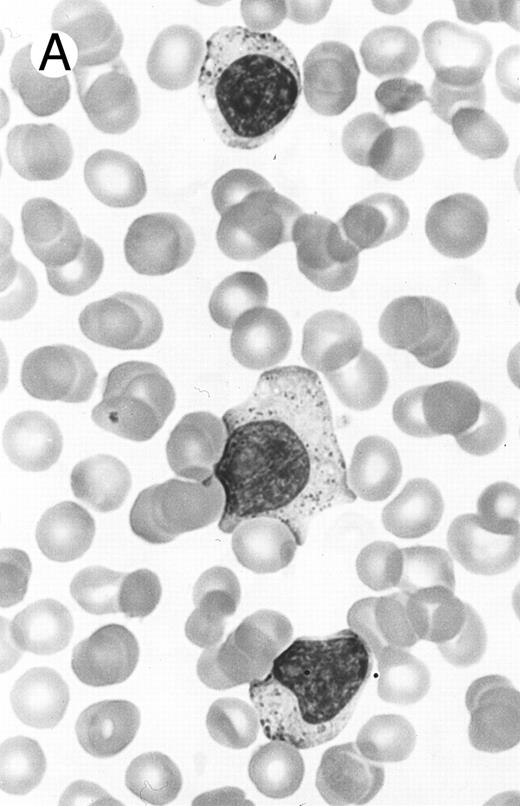

Abstract
Expression of the natural killer (NK) cell antigen CD56 is uncommon among lymphomas, and those that do are almost exclusively of non–B-cell lineage and show a predilection for the nasal and nasopharyngeal region. This study analyzes 49 cases of nonnasal CD56+ lymphomas, the largest series to date, to characterize the clinicopathologic spectrum of these rare neoplasms. All patients were Chinese. Four categories could be delineated. (1) Nasal-type NK/T cell lymphoma (n = 34) patients were adults 21 to 76 years of age (median, 50 years), including 25 men and 9 women. They presented with extranodal disease, usually in multiple sites. The commonest sites of involvement were skin, upper aerodigestive tract, testis, soft tissue, gastrointestinal tract, and spleen. Only 7 cases (21%) apparently had stage I disease. The neoplastic cells were often pleomorphic, with irregular nuclei and granular chromatin, and angiocentric growth was common. The characteristic immunophenotype was CD2+ CD3/Leu4− CD3ε+ CD56+, and 32 cases (94%) harbored Epstein-Barr virus (EBV). Follow-up information was available in 29 cases: 24 died at a median of 3.5 months; 3 were alive with relapse at 5 months to 2.5 years; and 2 were alive and well at 3 and 5 years, respectively. (2) Aggressive NK cell leukemia/lymphoma (n = 5) patients presented with hepatomegaly and blood/marrow involvement, sometimes accompanied by splenomegaly or lymphadenopathy. The neoplastic cells often had round nuclei and azurophilic granules in the pale cytoplasm. All cases exhibited an immunophenotype of CD2+ CD3/Leu4− CD56+ CD16− CD57− and all were EBV+. All of these patients died within 6 weeks. (3) In blastoid NK cell lymphoma (n = 2), the lymphoma cells resembled those of lymphoblastic or myeloid leukemia. One case studied for CD2 was negative and both cases were EBV−. One patient was alive with disease at 10 months and one was a recent case. (4) Other specific lymphoma types with CD56 expression (n = 8) included one case each of hepatosplenic γδ T-cell lymphoma and S100 protein+ T-cell lymphoproliferative disease and two cases each of T-chronic lymphocytic/prolymphocytic leukemia, lymphoblastic lymphoma, and true histiocytic lymphoma. All of these cases were EBV−. Six patients died at a median of 6.5 months. Nonnasal CD56+ lymphomas are heterogeneous, but all pursue a highly aggressive clinical course. The nasal-type NK/T-cell lymphoma and aggressive NK cell leukemia/lymphoma show distinctive clinicopathologic features and a very strong association with EBV. Blastoid NK cell lymphoma appears to be a different entity and shows no association with EBV.
CD56 ANTIBODY, a natural killer (NK) cell marker, recognizes the neuronal cell adhesion molecule (N-CAM).1 CD56 is rarely expressed in lymphomas and leukemias. In our previous study on 149 non-Hodgkin's lymphomas in a Chinese population, none of 95 B-cell lymphomas showed reactivity, whereas 12 (24%) of 51 T-cell lymphomas were CD56+.2 An interesting finding was that the great majority of the CD56+ lymphomas occurred in the nasal or nasopharyngeal region. This finding has subsequently led to characterization of the CD56+ T-cell lymphomas of the nasal cavity and nasopharynx as a distinctive clinicopathologic entity, currently referred to as angiocentric lymphoma in the REAL classification or as nasal T/NK or NK/T-cell lymphoma because of uncertainties regarding its true lineage.3-11 The nasal NK/T-cell lymphomas are more common among Orientals, Mexicans, and South Americans than Western populations and may show the dramatic presentation as midfacial destructive disease.12-15 They can exhibit a broad morphologic spectrum and may show angiocentric and angiodestructive growth. Zonal tumor cell death is common and can be so massive that a biopsy may not be able to yield a definitive diagnosis. The immunophenotypic profile is highly characteristic: CD2+, surface CD3 (Leu4)−, cytoplasmic CD3ε+, CD56+, and frequently negative for other T-lineage markers.3,5,11,15,16 Most studies have failed to show rearrangements of the T-cell receptor genes; thus, this does not appear to be a usual T-cell lymphoma.3,10,17-20 Epstein-Barr virus (EBV) can be demonstrated in almost all cases, irrespective of the ethnic origin of the patients; no other lymphoma type shows such a consistent and strong association with EBV.4,10,13 21-24
In 1992, our group25 and Kern et al26 almost simultaneously drew attention to a group of nonnasal lymphomas that are morphologically, immunophenotypically, and biologically similar to the nasal/nasopharyngeal NK/T-cell lymphomas. These tumors show predominant extranodal location and a highly aggressive clinical course and thus may represent an important form of extranodal lymphoma. Nonetheless, available information on this group of neoplasms is very limited, with most series including only a single case or a few cases.16,27-33 There is also recent controversy on its strength of association with EBV, with our study on 15 cases yielding a figure of 67%34 and a recent study of 9 cases from Japan giving a figure of only 33%.29 Therefore, in this study, we review our experience with 49 cases to provide a more complete picture of this uncommon entity and to clarify discrepancies. The nasal examples of CD56+ lymphomas are excluded from this analysis, because it is more logical to compare them with the T-cell and B-cell lymphomas occurring in the same anatomic region (manuscript submitted for publication).
PATIENTS AND METHODS
All examples of nonnasal CD56+ lymphomas or lymphoid leukemias seen at the Department of Pathology, Queen Elizabeth Hospital, Hong Kong, during the period 1980 through 1996, were reviewed. The CD56 status was determined immunohistochemically on frozen sections or cell smears using the antibody NKH1 (Coulter, Hialeah, FL) or on paraffin sections using the antibody 123C3 (Monosan, Uden, The Netherlands). In a previous study, we have shown that 123C3 can reliably detect CD56 expression in lymphomas on paraffin-embedded tissues.35 Forty-nine cases were identified, including 40 cases treated at the Queen Elizabeth Hospital and 9 cases in which the pathologic materials were seen in consultation. Twenty-six of these cases have previously been included in studies on angiocentric T-cell lymphomas (the CD56 status being known in only a small percentage of cases then), large granular lymphocytic leukemia, various aspects of CD56+ lymphomas, and various lymphoma types.25,27,28,34 36-41
The clinical data and follow-up information were collected. Available histologic materials were reviewed together with the immunophenotypic data. EBV was demonstrated using nonisotopic in situ hybridization for EBV-encoded small RNAs (EBERs), as previously described.4
RESULTS
Several groups with different clinicopathologic features can be delineated among these 49 cases (Table 1).
Nasal-type NK/T-cell lymphoma (n = 34).This group included 25 men and 9 women, 21 to 76 years of age, with a mean age of 50.2 years and a median age of 50 years. All except 1 patient presented with extranodal disease, often involving more than one site. Case no. 14 presented with cervical lymphadenopathy, but there were also a tonsillar mass and bone marrow involvement at presentation. Lymph node enlargement accompanied extranodal disease in 4 cases. The commonest major sites of involvement at diagnosis were skin (14 cases), upper aerodigestive tract (8 cases), testis (5 cases), soft tissues (4 cases), gastrointestinal tract (4 cases), and spleen (4 cases). For those presenting with skin disease, the lesions were generalized or distributed over multiple anatomic locations. Only 7 (20.6%) patients (cases no. 5, 13, 18, 24, 27, 31, and 33) had possible stage I disease at presentation, but 4 of them developed additional sites of disease within 1 year, and the other 3 relapsed at 2 to 3 years. Five patients had reactive hemophagocytic syndrome at presentation, resulting in marked pancytopenia, and 1 further patient developed the syndrome terminally.
The disease often pursued a rapidly progressive course, with additional sites of disease appearing rapidly within weeks to months. The new sites of involvement were also mostly extranodal and were similar to the predilection sites at presentation. Response to multiagent chemotherapy (such as CHOP, BACOP, or ProMACE-CytaBOM) was often poor; even if complete remission could be attained, relapse developed soon after. Among 29 patients with follow-up information, 24 died in 1 week to 3 years, with a median of 3.5 months. Five were alive, with 2 being disease-free at 3 years and 5 years, respectively, and 3 with relapse at 5 months, 2 years, and 2.5 years, respectively.
Nasal-type NK/T-cell lymphoma presenting as nodular skin lesion (case no. 28). (A) The skin shows focal necrosis of the epidermis and ulceration (arrow). (B) The lymphoid infiltrate in the dermis shows angiocentricity, as evidenced of the higher density of cells in the expanded walls of the blood vessels (arrows).
Nasal-type NK/T-cell lymphoma presenting as nodular skin lesion (case no. 28). (A) The skin shows focal necrosis of the epidermis and ulceration (arrow). (B) The lymphoid infiltrate in the dermis shows angiocentricity, as evidenced of the higher density of cells in the expanded walls of the blood vessels (arrows).
Histologically, the lymphomatous infiltrate was diffuse or patchy, with angiocentric and angiodestructive growth being observed in 30 cases (88.2%) (Figs 1 and 2). The cytologic composition was variable from case to case, including predominance of small cells, medium-sized cells, or large cells, or a mixture of these cell types (Fig 2 and 3). The tumor cell nuclei frequently showed irregular foldings and granular chromatin (Fig 2B). The larger cells possessed distinct nucleoli. The cytoplasm was moderate in amount and often pale. Karyorrhexis was usually prominent. Zonal tumor cell death, focal or confluent, was evident in 27 cases. In the 14 cases for which Giemsa-stained touch preparations were available, azurophilic granules could be identified in at least some of the neoplastic cells.
Laryngeal nasal-type NK/T-cell lymphoma relapsing as perforation of the terminal ileum (case no. 33). (A) The small bowel mucosa shows extensive necrosis and ulceration in the right field. There is also transmural lymphomatous infiltration. Note the vascular occlusion by lymphoma (arrow). (B) Higher magnification shows large and medium-sized lymphoma cells with irregular nuclear contours. The chromatin is fairly dense.
Laryngeal nasal-type NK/T-cell lymphoma relapsing as perforation of the terminal ileum (case no. 33). (A) The small bowel mucosa shows extensive necrosis and ulceration in the right field. There is also transmural lymphomatous infiltration. Note the vascular occlusion by lymphoma (arrow). (B) Higher magnification shows large and medium-sized lymphoma cells with irregular nuclear contours. The chromatin is fairly dense.
Cutaneous nasal-type NK/T-cell lymphoma (case no. 34). (A) This biopsy was initially misinterpreted as vasculitic lesion because of the small size of the lymphoid cells and the minimal cellular atypia. (B) Large numbers of lymphoid cells in the skin show positive labeling for EBERs on in situ hybridization. The sweat gland in the left field is negative.
Cutaneous nasal-type NK/T-cell lymphoma (case no. 34). (A) This biopsy was initially misinterpreted as vasculitic lesion because of the small size of the lymphoid cells and the minimal cellular atypia. (B) Large numbers of lymphoid cells in the skin show positive labeling for EBERs on in situ hybridization. The sweat gland in the left field is negative.
Cutaneous nasal-type NK/T-cell lymphoma, with the lymphoma cells showing cell membrane staining for CD56 on paraffin section. The sweat gland in the lower field is not stained.
Cutaneous nasal-type NK/T-cell lymphoma, with the lymphoma cells showing cell membrane staining for CD56 on paraffin section. The sweat gland in the lower field is not stained.
Two different cases of aggressive NK cell leukemia/lymphoma. (A) Peripheral blood shows increased large granular lymphocytes, most of which are mature-looking (case no. 36). The cell in the center is slightly less mature. (B) Buffy coat smear shows immature large granular lymphocytes with more open chromatin and distinct nucleoli (arrows) (case no. 37). Myeloid cells are seen in the background.
Two different cases of aggressive NK cell leukemia/lymphoma. (A) Peripheral blood shows increased large granular lymphocytes, most of which are mature-looking (case no. 36). The cell in the center is slightly less mature. (B) Buffy coat smear shows immature large granular lymphocytes with more open chromatin and distinct nucleoli (arrows) (case no. 37). Myeloid cells are seen in the background.
Lymph node biopsy of aggressive NK cell leukemia/lymphoma (case no. 37). There is a fairly monotonous, diffuse infiltrate of medium-sized cells with round nuclei. The neoplastic cells in this case resemble plasmacytoid monocytes.
Lymph node biopsy of aggressive NK cell leukemia/lymphoma (case no. 37). There is a fairly monotonous, diffuse infiltrate of medium-sized cells with round nuclei. The neoplastic cells in this case resemble plasmacytoid monocytes.
Immunocytochemical staining of aggressive NK cell leukemia/lymphoma (case no. 39), using the labeled avidin-biotin alkaline phosphatase system. The smears were prepared from mononuclear cells separated by density gradient centrifugation using Ficoll-Isopaque. (A) The cells are positive for CD2. (B) There is no reactivity for Leu4/CD3; the strongly stained small lymphocytes serve as internal positive controls. (C) The cells are reactive for CD56 (NKH1).
Immunocytochemical staining of aggressive NK cell leukemia/lymphoma (case no. 39), using the labeled avidin-biotin alkaline phosphatase system. The smears were prepared from mononuclear cells separated by density gradient centrifugation using Ficoll-Isopaque. (A) The cells are positive for CD2. (B) There is no reactivity for Leu4/CD3; the strongly stained small lymphocytes serve as internal positive controls. (C) The cells are reactive for CD56 (NKH1).
Blastoid NK cell lymphoma (case no. 40). (A) Biopsy shows a diffuse lymphomatous infiltrate with a prominent single-file pattern. (B) The neoplastic cells are medium-sized and possess fine chromatin. Mitotic figures are seen. There is remarkable resemblance to myeloid leukemic infiltration.
Blastoid NK cell lymphoma (case no. 40). (A) Biopsy shows a diffuse lymphomatous infiltrate with a prominent single-file pattern. (B) The neoplastic cells are medium-sized and possess fine chromatin. Mitotic figures are seen. There is remarkable resemblance to myeloid leukemic infiltration.
By definition, the neoplastic cells showed CD56 expression (Fig 4). All except 2 cases (cases no. 7 and 12) reacted with the polyclonal CD3ε antibody on paraffin sections, but both CD3ε− cases were immunoreactive for CD43 and CD45RO. Among 18 cases in which frozen tissue was available for analysis, all were CD2+; 1 case each stained for CD3/Leu4 (weak staining), CD7, and CD8 and all cases were negative for CD4, CD5, CD16, CD57, and B-lineage markers. Thirty-two (94.1%) cases showed labeling for EBERs in practically all neoplastic cells (Fig 3B); 2 cases were negative.
Aggressive NK cell leukemia/lymphoma (n = 5).These 5 patients were adults 37 to 54 years of age, with a mean age of 44.2 years and a median age of 41 years. They presented with fever and systemic symptoms and were found to have hepatomegaly, anemia, leukopenia, and thrombocytopenia (Table 2). Enlarged spleen was detected in 3 patients and enlarged lymph nodes in 2. Only 1 patient had skin rash. One patient had features of reactive hemophagocytic syndrome. The disease pursued a fulminant course, with rapid development of multiorgan failure. All 5 patients died within 6 weeks, some before a definitive diagnosis could be made or before treatment could be initiated. Postmortem examination was performed in 2 patients (cases no. 35 and 36), showing tumor involvement of multiple organs.
There were very few to numerous granular lymphocytes in the peripheral blood. Some of the granular lymphocytes were indistinguishable from normal large granular lymphocytes, with round nuclei, dense chromatin, and pale cytoplasm with fine azurophilic granules (Fig 5A). Some granular lymphocytes had larger nuclei with more open chromatin and distinct nucleoli (Fig 5B); occasional nuclei could show indentations. The azurophilic granules were sometimes large and coarse. There were also circulating normoblasts and immature myeloid cells. Marrow involvement ranged from subtle to extensive. In histologic sections, irrespective of site, there was a monotonous infiltrate of medium-sized cells with round nuclei and fairly condensed chromatin (Fig 6). Karyorrhexis was prominent. The infiltrate was diffuse, interstitial, or angiocentric.
The immunophenotype as analyzed on fresh/frozen tissues was CD2+ CD3/Leu4− CD4− CD5− CD7− CD8− CD16− CD56+ CD57− (Fig 7). In paraffin sections, the neoplastic cells showed reactivity with the polyclonal CD3ε antibody. In all cases, nuclear labeling for EBER was observed in the majority of neoplastic cells.
Blastoid NK cell lymphoma (n = 2).One patient presented with systemic disease, whereas 1 had localized disease at presentation. Histologically, the infiltrate was diffuse, with a prominent single-file pattern reminiscent of leukemia (Fig 8A). The neoplastic cells were medium-sized and had irregularly folded delicate nuclear membranes, fine chromatin, and tiny nucleoli (Fig 8B). Mitotic figures were easily identified.
In case no. 40, the immunophenotype was CD2− CD3/Leu4− CD4− CD5− CD7+ CD8− CD13− CD33+ CD56+, as analyzed on fresh tissue, and CD3ε+ (weak) CD43+ CD56+ CD68− TdT− and myeloperoxidase-negative on paraffin sections. In case no. 41, the immunophenotype as assessed on paraffin section was CD3ε+ CD43+ CD56+ TdT− and myeloperoxidase-negative. Both cases were EBERs-negative.
Specific lymphoma types with CD56 expression (n = 8).The clinical findings, diagnoses, and immunophenotype of the 8 cases of specific lymphoma types with CD56 expression are listed in Tables 1 and 3. Six of the patients have died at a median of 6.5 months. One patient is alive at 4 years after chemotherapy, and 1 is only recently diagnosed as having lymphoma.
For case no. 46, the neoplastic cells showed classical features of lymphoblasts and strong staining with the polyclonal CD3ε antibody on paraffin section, but they also showed reactivity with two myeloid-associated markers, CD13 and CD33, but not myeloperoxidase. This could represent a hybrid T-cell/myeloid immunophenotype. All 8 cases were EBERs-negative.
DISCUSSION
CD56+ malignant lymphomas are uncommon. The 49 cases of nonnasal examples included in this series were collected over a 16-year period in a geographic location where this lymphoma type appears to be more prevalent than most other places of the world. Over the same period, we have encountered approximately 70 cases of nasal/nasopharyngeal CD56+ lymphomas. Nonnasal CD56+ lymphomas comprise at least four different entities, and their salient features are summarized in Table 4, based on information from the current study and the literature.
Nasal-type NK/T-cell lymphoma is the commonest type of CD56+ lymphoma occurring outside the nasal or nasopharyngeal region. It is morphologically and immunohistochemially identical to nasal NK/T-cell lymphoma. This study confirms it to be a form of extranodal lymphoma with predilection for the skin, upper aerodigestive tract, testis, gastrointestinal tract, soft tissues, and spleen. It is of interest that these are also the same sites that both the nasal/nasopharyngeal and nasal-type CD56+ lymphomas tend to disseminate to. It has been postulated that these sites may richly express CD56 (N-CAM), favoring homing of CD56+ lymphoma cells, because N-CAM shows homophilic binding properties.1 This lymphoma type is associated with an increased risk of developing hemophagocytic syndrome (17.6% [6 of 34]); the systemic histiocytic activation presumably results from cytokines or other products released by the lymphoma cells.42 The high mortality rate (82.8%) and very short median survival observed in this study corroborates the aggressive behavior documented in the small series and case reports in the literature.7,9,16,25-33 43 This is probably the most aggressive currently known lymphoma type. Even patients receiving third-generation combination chemotherapy have an unfavorable outcome. Despite initial response to therapy in some patients, relapse usually occurs within a short time. There are thus strong reasons to design new strategies of treatment for this group of highly aggressive lymphoma. For comparison, although the nasal CD56+ NK/T-cell lymphomas are more aggressive than the nasal T-cell or B-cell lymphomas, the 2-year actuarial disease-free survival of 31% ± 13% (unpublished observation) appears to be much better than that of nasal-type NK/T-cell lymphomas. Nonetheless, the difference can be attributed to the predominance of stage I/II disease (82.3%) for the nasal NK/T-cell lymphomas and predominance of advanced stage disease at presentation for nasal-type NK/T-cell lymphomas.
It is currently unclear whether the nasal-type NK/T-cell lymphomas are bona fide NK cell neoplasms or T-cell neoplasms with CD56 expression, hence the noncommittal lineage designation NK/T.9 This designation is descriptively more accurate than angiocentric lymphoma6 because angiocentric growth is not invariably seen in this lymphoma type and angiocentricity can be observed in other lymphoma types, including B-cell lymphomas.44-46 It is not surprising that there are great difficulties in distinguishing between NK and T-cell lineage, because these two lineages are so closely related; in fact, a bipotential T/NK progenitor cell probably exists.47 Features favoring an NK cell lineage are the lack of surface CD3 (Leu4) expression, lack of expression of T-cell antigen receptors, presence of azurophilic granules, and lack of T-cell receptor gene rearrangements in the great majority of cases studied.16,30,33,46,48,49 Nonetheless, lack of expression of other NK cells markers such as CD16 and CD57 is somewhat unusual for cells of NK lineage. This study also establishes a strong association of this lymphoma type with EBV (94.1% [32 of 34]), comparable to the nasal counterpart. NK/T-cell lymphoma (nasal and nasal-type) is the malignant lymphoma type most strongly associated with EBV in all geographic areas studied.24 The strength of association as reported in our previous study on 15 cases was lower (67%) because of inclusion of specific types of T-cell lymphomas with CD56 expression; if only the nasal-type NK/T-cell lymphomas are considered, the positivity rate is 100% (7 of 7).34 The low figure of 33% recently reported from Japan by Kobashi et al29 is due to the inclusion of 5 cases of blastoid NK cell lymphoma (all EBV-negative); if such cases are excluded, the EBV positivity rate for the nasal-type NK/T-cell lymphomas is 75% (3 of 4). Some recent studies on nasal-type NK/T-cell lymphomas in caucasian populations, albeit small in size, also support a strong although not invariable association with EBV.33 48
Although aggressive NK cell leukemia/lymphoma is identical to nasal-type NK/T-cell lymphoma in the presence of azurophilic granules, immunophenotypic profile (CD2+ CD3/Leu4− CD56+ CD16−/+ CD57−), genotype (lack of T-cell receptor gene rearrangements), and strong association with EBV,39,50-60 it does show some distinguishing features: (1) younger age group (mean age for this series was 44.2 years, and for a Japanese series of 11 cases was 29.5 years50 ); (2) the presence of peripheral blood involvement (albeit minimal in some); (3) more frequent occurrence of superficial lymphadenopathy; (4) very infrequent skin involvement; (5) more monotonous-appearing neoplastic population; and (6) predominantly round nuclear contour.21,50,51,54,61 However, admittedly some cases with systemic disease cannot be reliably classified as nasal-type NK/T-cell lymphoma or aggressive NK cell leukemia/lymphoma. Patients with nasal NK/T-cell lymphoma have also been rarely reported to develop features of aggressive NK cell leukemia/lymphoma.62
Aggressive NK cell leukemia/lymphoma is not a usual form of leukemia, because bone marrow involvement is often patchy and may even be minimal; thus a designation of leukemia/lymphoma is justified. The clinical course is usually fulminant, with the patients dying shortly after presentation from multiorgan failure. Like nasal and nasal-type NK/T-cell lymphomas, it may also be associated with reactive hemophagocytic syndrome.52,63 The tumor cells can exhibit a spectrum of cytologic appearances from mature-looking cells to larger cells and cells with prominent nucleoli. Those cases composed of mature-looking granular lymphocytes are indistinguishable from T-cell large granular lymphocytic (LGL) leukemia on morphologic grounds, but a distinction is important because of many important differences. T-cell LGL leukemia is associated with severe neutropenia and rheumatoid arthritis and pursues an extremely indolent course. Special studies are most helpful for making a distinction, because T-cell LGL leukemia frequently exhibits an immunophenotype of CD3/Leu4+ CD8+ CD57+ CD16+/− CD56−, clonal rearrangements of T-cell receptor genes, and lack of association with EBV.64-68 It has been suggested that lack of CD57 expression or expression of CD56 may be associated with a more aggressive course in T-cell LGL leukemia,69,70 but this is not a universal finding.71 On the other hand, not all proliferations of CD3/Leu4− CD56+ large granular lymphocytes pursue an aggressive course.64 The indolent examples differ from the aggressive ones in absence of fever, lack of hepatosplenomegaly or lymphadenopathy, frequent expression of CD16 and CD57, and lack of EBV association.56,65 71
Blastoid NK cell lymphoma has only been recently characterized.29 It shows extranodal presentation and can also rarely arise in the nasal cavity.72 The case reported by Kawano et al73 may represent another such example. This entity appears to be biologically distinct from the NK/T-cell lymphomas in the lymphoblastoid or myeloid leukemia-like morphology, often CD2− immunophenotype, and lack of EBV association. The behavior of this tumor remains to be clarified, because very few cases have been reported so far. The relationship with the entity myeloid/NK cell leukemia also requires clarification.74
Various specific lymphoma types can uncommonly express CD56, such as lymphoblastic lymphoma, peripheral T-cell lymphoma, and true histiocytic lymphoma. The basis for this phenomenon is unclear. For lymphoblastic lymphoma, a previous study has shown expression of the NK cell-associated markers CD16 and CD57 to be associated with a worse prognosis, although CD56 expression has not been analyzed in that study.75 T-lymphoblastic lymphoma expressing CD56 has indeed been recently reported by Ichinohasama et al.76 Peripheral T-cell lymphoma expressing CD56, sometimes referred to as NK-like T-cell lymphoma, are bona fide T-cell neoplasms because they often (but not invariably) express CD3/Leu4 and show rearrangements of the T-cell receptor genes.77 The aggressive behavior of these CD56+ peripheral T-cell lymphomas has also been documented in a number of studies.26,77-81 CD56 expression among peripheral T-cell lymphomas is in fact very rare, but two specific subtypes show a very high frequency of CD56 expression, at least in the small number of cases in which this marker has been studied, namely hepatosplenic γδ T-cell lymphoma and S100 protein+ T-cell lymphoma.41 82-84 These lymphoma types show overlapping clinical and pathologic features and are known to be aggressive. Another interesting finding from this study is that some true histiocytic lymphomas can also express CD56; thus, CD56 expression among lymphomas is not strictly limited to those of T-cell or putative NK cell lineage.
In conclusion, a number of entities are encompassed in the family of CD56+ malignant lymphomas, including several distinctive putative NK cell neoplasms and CD56-expressing peripheral T-cell lymphomas. Nonetheless, they are unified by the common theme of highly aggressive behavior. Therefore, in the immunophenotypic analysis of T-cell lymphomas, routine application of the CD56 marker may help to identify this group of neoplasm.
Address reprint requests to John K.C. Chan, MD, Department of Pathology, Queen Elizabeth Hospital, Wylie Road, Kowloon, Hong Kong.